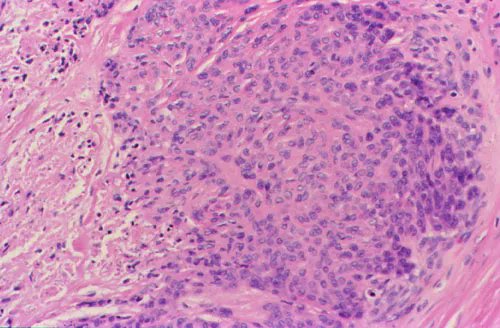
The most common sarcoma in the hand, epithelioid sarcoma, can mimic GA or rheumatoid nodule. Best screening test is pan-keratin, as ES always is +. INI1 while helpful may be retained in up to 10% of cases. I never like doing a "negative test" for screening. #BSTpath <a href="/CCFPathRes/">Cleveland Clinic Pathology Residency</a>

Odharnaith Ní Bhriain
@odharnaitho
Consultant Pathologist #gupath #hemepath
ID: 4221903327
18-11-2015 23:37:10
154 Tweet
180 Followers
379 Following


An mbeimid ábalta caillteanas gnáthóige a stopadh agus cuidiú leis an nádúr teacht chuige féin arís? Beidh Darach Ó Murchú á fhiosrú anocht ar Cumhacht an Nádúir 21:30. Office of Public Works Pádraic Fogarty Irish Wildlife Trust Department of Housing, Local Government & Heritage Ecofact






You could win return flights for you and your bestie with Air Canada to Toronto, Canada. When you've seen all the city has to offer, you can take a trip to Niagara Falls, just an hour away by car. To enter, just FOLLOW & RT 👍 T&C’s: ow.ly/jndR50G35IC




The most common sarcoma in the hand, epithelioid sarcoma, can mimic GA or rheumatoid nodule. Best screening test is pan-keratin, as ES always is +. INI1 while helpful may be retained in up to 10% of cases. I never like doing a "negative test" for screening. #BSTpath Cleveland Clinic Pathology Residency

As mentioned by many, this is Cystic trophoblastic tumour in a post chemo orchidectomy specimen. Degenerate remnants of choriocarcinoma after systemic chemo. hCG should only be mildly raised. As mentioned by Andres Martin Acosta (Andy): these tumours should be treated conservatively.














